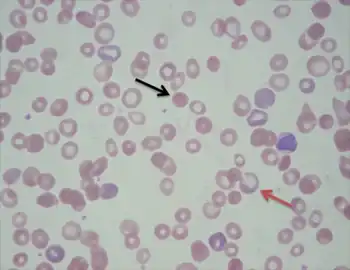

Hemolytic anemia
| Hemolytic anemia | |
|---|---|
| Other names: Haemolytic anaemia | |
![]() | |
| Figure shows normal red blood cells flowing freely in a blood vessel. The inset image shows a cross-section of a normal red blood cell with normal hemoglobin.[1] | |
| Specialty | Hematology |
| Causes | Hemolysis |
Hemolytic anemia is a form of anemia due to hemolysis, the abnormal breakdown of red blood cells (RBCs), either in the blood vessels (intravascular hemolysis) or elsewhere in the human body (extravascular).[2] This most commonly occurs within the spleen, but also can occur in the reticuloendothelial system or mechanically (prosthetic valve damage).[2] Hemolytic anemia accounts for 5% of all existing anemias.[2] It has numerous possible consequences, ranging from general symptoms to life-threatening systemic effects.[2] The general classification of hemolytic anemia is either intrinsic or extrinsic.[3] Treatment depends on the type and cause of the hemolytic anemia.[2]
Symptoms of hemolytic anemia are similar to other forms of anemia (fatigue and shortness of breath), but in addition, the breakdown of red cells leads to jaundice and increases the risk of particular long-term complications, such as gallstones[4] and pulmonary hypertension.[5]
Signs and symptoms
Symptoms of hemolytic anemia are similar to the general signs of anemia.[2] General signs and symptoms include: fatigue, pallor, shortness of breath, and tachycardia.[2] In small children, failure to thrive may occur in any form of anemia.[6][7] In addition, symptoms related to hemolysis may be present such as chills, jaundice, dark urine, and an enlarged spleen.[2] Certain aspects of the medical history can suggest a cause for hemolysis, such as drugs, medication side effects, autoimmune disorders, blood transfusion reactions, the presence of prosthetic heart valve, or other medical illness.[2]
Chronic hemolysis leads to an increased excretion of bilirubin into the biliary tract, which in turn may lead to gallstones.[8] The continuous release of free hemoglobin has been linked with the development of pulmonary hypertension (increased pressure over the pulmonary artery); this, in turn, leads to episodes of syncope (fainting), chest pain, and progressive breathlessness.[9] Pulmonary hypertension eventually causes right ventricular heart failure, the symptoms of which are peripheral edema (fluid accumulation in the skin of the legs) and ascites (fluid accumulation in the abdominal cavity).[9]
Causes
They may be classified according to the means of hemolysis, being either intrinsic in cases where the cause is related to the red blood cell (RBC) itself, or extrinsic in cases where factors external to the RBC dominate.[10] Intrinsic effects may include problems with RBC proteins or oxidative stress handling, whereas external factors include immune attack and microvascular angiopathies (RBCs are mechanically damaged in circulation).[2][3]
Intrinsic causes
Hereditary (inherited) hemolytic anemia can be due to :
- Defects of red blood cell membrane production (as in hereditary spherocytosis and hereditary elliptocytosis).[2]
- Defects in hemoglobin production (as in thalassemia, sickle-cell disease and congenital dyserythropoietic anemia).[2]
- Defective red cell metabolism (as in glucose-6-phosphate dehydrogenase deficiency and pyruvate kinase deficiency).[11][12]
- Wilson's disease may infrequently present with hemolytic anemia without due to excessive inorganic copper in blood circulation, which destroys red blood cells (though the mechanism of hemolysis is still unclear).[13]
Extrinsic causes
Acquired hemolytic anemia may be caused by immune-mediated causes, drugs, and other miscellaneous causes.[2]
- Immune-mediated causes could include transient factors as in Mycoplasma pneumoniae infection (cold agglutinin disease)[14] or permanent factors as in autoimmune diseases like autoimmune hemolytic anemia[15] (itself more common in diseases such as systemic lupus erythematosus, rheumatoid arthritis, Hodgkin's lymphoma, and chronic lymphocytic leukemia).[2]
- Spur cell hemolytic anemia[16]
- Any of the causes of hypersplenism (increased activity of the spleen), such as portal hypertension.[17]
- Acquired hemolytic anemia is also encountered in burns and as a result of certain infections (e.g. malaria).[15][18]
- Paroxysmal nocturnal hemoglobinuria (PNH), sometimes referred to as Marchiafava-Micheli syndrome, is a rare, acquired, potentially life-threatening disease of the blood characterized by complement-induced intravascular hemolytic anemia.[19]
- Lead poisoning resulting from the environment causes non-immune hemolytic anemia.[20]
- Similarly, poisoning by arsine or stibine also causes hemolytic anemia.[21]
- Runners can suffer hemolytic anemia due to "footstrike hemolysis", owing to the destruction of red blood cells in feet at foot impact.[22][23]
- Low-grade hemolytic anemia occurs in 70% of prosthetic heart valve recipients, and severe hemolytic anemia occurs in 3%.[24]
Mechanism
In hemolytic anemia, there are two principal mechanisms of hemolysis; intravascular and extravascular.[25]
Intravascular hemolysis
Intravascular hemolysis describes hemolysis that happens mainly inside the vasculature.[26] As a result, the contents of the red blood cell are released into the general circulation, leading to hemoglobinemia[27] and increasing the risk of ensuing hyperbilirubinemia.[28]
Intravascular hemolysis may occur when red blood cells are targeted by autoantibodies, leading to complement fixation, or by damage by parasites such as Babesia.[29]
Extravascular hemolysis
Extravascular hemolysis refers to hemolysis taking place in the liver, spleen, bone marrow, and lymph nodes.[26] In this case little hemoglobin escapes into blood plasma.[28] The macrophages of the reticuloendothelial system in these organs engulf and destroy structurally-defective red blood cells, or those with antibodies attached, and release unconjugated bilirubin into the blood plasma circulation.[30][31] Typically, the spleen destroys mildly abnormal red blood cells or those coated with IgG-type antibodies,[32][33] while severely abnormal red blood cells or those coated with IgM-type antibodies are destroyed in the circulation or in the liver.[32]
If extravascular hemolysis is extensive, hemosiderin can be deposited in the spleen, bone marrow, kidney, liver, and other organs, resulting in hemosiderosis.[28]
In a healthy person, a red blood cell survives 90 to 120 days in the circulation, so about 1% of human red blood cells break down each day.[34] The spleen (part of the reticulo-endothelial system) is the main organ that removes old and damaged RBCs from the circulation.[2] In healthy individuals, the breakdown and removal of RBCs from the circulation is matched by the production of new RBCs in the bone marrow.[2]
In conditions where the rate of RBC breakdown is increased, the body initially compensates by producing more RBCs; however, breakdown of RBCs can exceed the rate that the body can make RBCs, and so anemia can develop.[34] Bilirubin, a breakdown product of hemoglobin, can accumulate in the blood, causing jaundice.[29]
In general, hemolytic anemia occurs as a modification of the RBC life cycle.[35] That is, instead of being collected at the end of its useful life and disposed of normally, the RBC disintegrates in a manner allowing free iron-containing molecules to reach the blood.[35] With their complete lack of mitochondria, RBCs rely on pentose phosphate pathway (PPP) for the materials needed to reduce oxidative damage. Any limitations of PPP can result in more susceptibility to oxidative damage and a short or abnormal lifecycle.[36] If the cell is unable to signal to the reticuloendothelial phagocytes by externalizing phosphatidylserine, it is likely to lyse through uncontrolled means.[37][38][39]
The distinguishing feature of intravascular hemolysis is the release of RBC contents into the blood stream. The metabolism and elimination of these products, largely iron-containing compounds capable of doing damage through Fenton reactions, is an important part of the condition. Several reference texts exist on the elimination pathways, for example.[40][41][42] Free hemoglobin can bind to haptoglobin, and the complex is cleared from the circulation; thus, a decrease in haptoglobin can support a diagnosis of hemolytic anemia. Alternatively, hemoglobin may oxidize and release the heme group that is able to bind to either albumin or hemopexin. The heme is ultimately converted to bilirubin and removed in stool and urine.[40] Hemoglobin may be cleared directly by the kidneys resulting in fast clearance of free hemoglobin but causing the continued loss of hemosiderin loaded renal tubular cells for many days.
Additional effects of free hemoglobin seem to be due to specific reactions with NO.[43]
Diagnosis
The diagnosis of hemolytic anemia can be suspected on the basis of a constellation of symptoms and is largely based on the presence of anemia, an increased proportion of immature red cells (reticulocytes) and a decrease in the level of haptoglobin, a protein that binds free hemoglobin. Examination of a peripheral blood smear and some other laboratory studies can contribute to the diagnosis. Symptoms of hemolytic anemia include those that can occur in all anemias as well as the specific consequences of hemolysis. All anemias can cause fatigue, shortness of breath, decreased ability to exercise when severe. Symptoms specifically related to hemolysis include jaundice and dark colored urine due to the presence of hemoglobin (hemoglobinuria). When restricted to the morning hemoglobinuria may suggest paroxysmal nocturnal haemoglobinuria. Direct examination of blood under a microscope in a peripheral blood smear may demonstrate red blood cell fragments called schistocytes, red blood cells that look like spheres (spherocytes), and/or red blood cells missing small pieces (bite cells). An increased number of newly made red blood cells (reticulocytes) may also be a sign of bone marrow compensation for anemia. Laboratory studies commonly used to investigate hemolytic anemia include blood tests for breakdown products of red blood cells, bilirubin and lactate dehydrogenase, a test for the free hemoglobin binding protein haptoglobin, and the direct Coombs test to evaluate antibody binding to red blood cells suggesting autoimmune hemolytic anemia.
Treatment
Definitive therapy depends on the cause:
- Symptomatic treatment can be given by blood transfusion, if there is marked anemia. A positive Coombs test is a relative contraindication to transfuse the patient. In cold hemolytic anemia there is advantage in transfusing warmed blood.
- In severe immune-related hemolytic anemia, steroid therapy is sometimes necessary.
- In steroid resistant cases, consideration can be given to rituximab or addition of an immunosuppressant (azathioprine, cyclophosphamide).
- Association of methylprednisolone and intravenous immunoglobulin can control hemolysis in acute severe cases.
- Sometimes splenectomy can be helpful where extravascular hemolysis, or hereditary spherocytosis, is predominant (i.e., most of the red blood cells are being removed by the spleen).[44]
Other animals
Hemolytic anemia affects nonhuman species as well as humans. It has been found, in a number of animal species, to result from specific triggers.[45]
Some notable cases include hemolytic anemia found in black rhinos kept in captivity, with the disease, in one instance, affecting 20% of captive rhinos at a specific facility.[46][47][48] The disease is also found in wild rhinos.[49]
Dogs and cats differ slightly from humans in some details of their RBC composition and have altered susceptibility to damage, notably, increased susceptibility to oxidative damage from consumption of onion. Garlic is less toxic to dogs than onion.[50]
References
- ↑ "Red Blood Cells". US National Library of Medicine. Archived from the original on 2017-01-01.
- 1 2 3 4 5 6 7 8 9 10 11 12 13 14 15 16 Capriotti, Theresa (2016). Pathophysiology : introductory concepts and clinical perspectives. Frizzell, Joan Parker. Philadelphia. ISBN 978-0-8036-1571-7. OCLC 900626405.
- 1 2 Philadelphia, The Children's Hospital of (2014-03-30). "Hemolytic Anemia". chop.edu. Archived from the original on 2020-02-25. Retrieved 2020-02-25.
- ↑ Trotman, BW (1991). "Pigment gallstone disease". Gastroenterology Clinics of North America. 20 (1): 111–26. ISSN 0889-8553. PMID 2022417.
- ↑ Machado, Roberto F.; Gladwin, Mark T. (2010). "Pulmonary Hypertension in Hemolytic Disorders". Chest. Elsevier BV. 137 (6): 30S–38S. doi:10.1378/chest.09-3057. ISSN 0012-3692. PMC 2882115. PMID 20522578.
- ↑ Kahre, Tiina; Teder, Maris; Panov, Maarja; Metspalu, Andres (2004). "Severe CF manifestation with anaemia and failure to thrive in a 394delTT homozygous patient". Journal of Cystic Fibrosis. Elsevier BV. 3 (1): 58–60. doi:10.1016/j.jcf.2003.12.009. ISSN 1569-1993. PMID 15463888.
- ↑ "Hypoproteinemia, Anemia, and Failure to Thrive in an Infant". Archived from the original on 2021-04-17. Retrieved 2022-01-15.
- ↑ Levitt, Robert E.; Ostrow, Donald J. (1980). "Hemolytic Jaundice and Gallstones". Gastroenterology. 78 (4): 821–830. doi:10.1016/0016-5085(80)90690-3. Archived from the original on 2021-04-17. Retrieved 2022-01-15.
- 1 2 Schrier, R. W., & Bansal, S. (2008). Pulmonary hypertension, right ventricular failure, and kidney: different from left ventricular failure?. Archived 2021-04-17 at the Wayback Machine Clinical journal of the American Society of Nephrology : CJASN, 3(5), 1232–1237. https://doi.org/10.2215/CJN.01960408
- ↑ Current Medical Diagnosis and Treatment 2009 By Stephen J. McPhee, Maxine A. Papadakis page 436 https://books.google.com/books?id=zQlH4mXSziYC&pg=PT454&dq=hemoglobin+hemosiderin+hemolysis+bilirubin&ei=Z2P_SuzwA6D2ygT9vOz3Dg#v=onepage&q=hemoglobin%20hemosiderin%20hemolysis%20bilirubin&f=false Archived 2021-05-20 at the Wayback Machine
- ↑ Eisa, Mahmoud S.; Mohamed, Shehab F.; Ibrahim, Firyal; Shariff, Khalid; Sadik, Nagham; Nashwan, Abdulqadir; Yassin, Mohamed A. (2019-11-01). "Paroxysmal Nocturnal Hemoglobinuria with Glucose-6-Phosphate Dehydrogenase Deficiency: A Case Report and Review of the Literature". Case Reports in Oncology. 12 (3): 838–844. doi:10.1159/000503817. ISSN 1662-6575. PMC 6873095. PMID 31762758.
- ↑ Grace, Rachael F.; Bianchi, Paola; van Beers, Eduard J.; Eber, Stefan W.; Glader, Bertil; Yaish, Hassan M.; Despotovic, Jenny M.; Rothman, Jennifer A.; Sharma, Mukta; McNaull, Melissa M.; Fermo, Elisa (2018-05-17). "Clinical spectrum of pyruvate kinase deficiency: data from the Pyruvate Kinase Deficiency Natural History Study". Blood. 131 (20): 2183–2192. doi:10.1182/blood-2017-10-810796. ISSN 0006-4971. PMID 29549173. Archived from the original on 2022-01-20. Retrieved 2022-01-15.
- ↑ Sharma, Sunita; Toppo, Anupa; Rath, B.; Harbhajanka, Aparna; Lalita Jyotsna, P. (September 2010). "Hemolytic Anemia as a Presenting Feature of Wilson's Disease: A Case Report". Indian Journal of Hematology and Blood Transfusion. 26 (3): 101–102. doi:10.1007/s12288-010-0034-2.
- ↑ Khoury, Tawfik; Abu Rmeileh, Ayman; Kornspan, Jonathan David; Abel, Roy; Mizrahi, Meir; Nir-Paz, Ran (2015-02-19). "Mycoplasma pneumoniae Pneumonia Associated With Methemoglobinemia and Anemia: An Overlooked Association?". Open Forum Infectious Diseases. 2 (1): ofv022. doi:10.1093/ofid/ofv022. ISSN 2328-8957. PMC 4438901. PMID 26034771.
- 1 2 Hill, Anita; Hill, Quentin A. (2018-11-30). "Autoimmune hemolytic anemia". Hematology. 2018 (1): 382–389. doi:10.1182/asheducation-2018.1.382. ISSN 1520-4391. PMC 6246027. PMID 30504336.
- ↑ Privitera, G., & Meli, G. (2016). An unusual cause of anemia in cirrhosis: spur cell anemia, a case report with review of literature. Gastroenterology and hepatology from bed to bench, 9(4), 335–339.
- ↑ Li, Hao; Guan, Dongyao; Xu, Junqiang; Jin, Enhao; Sun, Shu (January 2020). "Atraumatic splenic rupture was attributed to intra-cystic haemorrhage and hypersplenism in a patient with cirrhosis and portal hypertension: A case report". SAGE Open Medical Case Reports. 8: 2050313X2090190. doi:10.1177/2050313X20901900. ISSN 2050-313X. PMC 6984417. PMID 32047630.
- ↑ Zahid, M. F., & Alsammak, M. S. (2018). Spurious Thrombocytosis in the Setting of Hemolytic Anemia and Microcytosis Secondary to Extensive Burn Injury. Turkish journal of haematology : official journal of Turkish Society of Haematology, 35(3), 205–206. https://doi.org/10.4274/tjh.2017.0466
- ↑ Brodsky, Robert A. (2014-10-30). "Paroxysmal nocturnal hemoglobinuria". Blood. 124 (18): 2804–2811. doi:10.1182/blood-2014-02-522128. ISSN 0006-4971. PMC 4215311. PMID 25237200.
- ↑ Valentine, W N; Paglia, D E; Fink, K; Madokoro, G (October 1976). "Lead poisoning: association with hemolytic anemia, basophilic stippling, erythrocyte pyrimidine 5'-nucleotidase deficiency, and intraerythrocytic accumulation of pyrimidines". Journal of Clinical Investigation. 58 (4): 926–932. doi:10.1172/JCI108545. ISSN 0021-9738. PMC 333255. PMID 965496.
- ↑ Correia, Nuno; Carvalho, Catarina; Friões, Fernando; Araújo, José P; Almeida, Jorge; Azevedo, Ana (2009-08-11). "Haemolytic anaemia secondary to arsenic poisoning: a case report". Cases Journal. 2: 7768. doi:10.4076/1757-1626-2-7768. ISSN 1757-1626. PMC 2769370. PMID 19918480.
- ↑ Telford RD, Sly GJ, Hahn AG, Cunningham RB, Bryant C, Smith JA (January 2003). "Footstrike is the major cause of hemolysis during running". J. Appl. Physiol. 94 (1): 38–42. doi:10.1152/japplphysiol.00631.2001. PMID 12391035. S2CID 5750453. Archived from the original on 2022-02-11. Retrieved 2022-01-15.
- ↑ Lippi G, Schena F, Salvagno GL, Aloe R, Banfi G, Guidi GC (July 2012). "Foot-strike haemolysis after a 60-km ultramarathon". Blood Transfus. 10 (3): 377–383. doi:10.2450/2012.0167-11. PMC 3417738. PMID 22682343.
- ↑ Wise, Donald Lee (2000). Biomaterials Engineering and Devices: Orthopedic, dental, and bone graft applications. ISBN 978-0-89603-859-2.
{{cite book}}: CS1 maint: url-status (link) - ↑ Dhaliwal G, Cornett PA, Tierney LM., Jr Hemolytic anemia. Am Fam Physician. 2004;69:2599–606. [PubMed] [Google Scholar]
- 1 2 Stanley L Schrier, MD. William C Mentzer, MD, Jennifer S Tirnauer, MD (eds.). "Diagnosis of hemolytic anemia in the adult". UpToDate. Archived from the original on 2017-12-26. Retrieved 2019-05-04.
- ↑ "Intravascular hemolysis". eClinpath. Retrieved 2019-05-08.
- 1 2 3 Muller, Andre; Jacobsen, Helene; Healy, Edel; McMickan, Sinead; Istace, Fréderique; Blaude, Marie-Noëlle; Howden, Peter; Fleig, Helmut; Schulte, Agnes (2006). "Hazard classification of chemicals inducing haemolytic anaemia: An EU regulatory perspective" (PDF). Regulatory Toxicology and Pharmacology. Elsevier BV. 45 (3): 229–241. doi:10.1016/j.yrtph.2006.04.004. hdl:10029/5596. ISSN 0273-2300. PMID 16793184. Retrieved 2019-05-04
- 1 2 "Bilirubin and hemolytic anemia". eClinpath. Retrieved 2019-05-08.
- ↑ Rhodes, Carl E.; Varacallo, Matthew (2019-03-04). "Physiology, Oxygen Transport". NCBI Bookshelf. PMID 30855920. Retrieved 2019-05-04.
- ↑ Sokol RJ, Hewitt S, Stamps BK (June 1981). "Autoimmune haemolysis: an 18-year study of 865 cases referred to a regional transfusion centre". Br Med J (Clin Res Ed). 282(6281): 2023–7. doi:10.1136/bmj.282.6281.2023. PMC 1505955. PMID 6788179.
- 1 2 BRAUNSTEIN.EVAN (2019-05-03). "Overview of Hemolytic Anemia – Hematology and Oncology". Merck Manuals Professional Edition (in Latin). Retrieved 2019-05-05.
- ↑ "Hypersplenism: MedlinePlus Medical Encyclopedia". MedlinePlus. 2019-04-30. Retrieved 2019-05-08.
- 1 2 Bosman, Giel J. C. G. M. (2013). "Survival of red blood cells after transfusion: processes and consequences". Frontiers in Physiology. 4: 376. doi:10.3389/fphys.2013.00376. ISSN 1664-042X. PMC 3866658. PMID 24391593.
- 1 2 Alaarg, Amr; Schiffelers, Raymond M.; van Solinge, Wouter W.; van Wijk, Richard (2013). "Red blood cell vesiculation in hereditary hemolytic anemia". Frontiers in Physiology. 4: 365. doi:10.3389/fphys.2013.00365. ISSN 1664-042X. PMC 3862113. PMID 24379786.
- ↑ Kosenko, Elena A.; Tikhonova, Lyudmila A.; Montoliu, Carmina; Barreto, George E.; Aliev, Gjumrakch; Kaminsky, Yury G. (2018-01-05). "Metabolic Abnormalities of Erythrocytes as a Risk Factor for Alzheimer's Disease". Frontiers in Neuroscience. 11: 728. doi:10.3389/fnins.2017.00728. ISSN 1662-453X. PMC 5760569. PMID 29354027.
- ↑ Kolb S, Vranckx R, Huisse MG, Michel JB, Meilhac O (July 2007). "The phosphatidylserine receptor mediates phagocytosis by vascular smooth muscle cells". The Journal of Pathology. 212 (3): 249–59. doi:10.1002/path.2190. PMID 17534843. S2CID 22923550.
- ↑ Bosman GJ, Willekens FL, Werre JM (2005). "Erythrocyte aging: a more than superficial resemblance to apoptosis?" (PDF). Cellular Physiology and Biochemistry. 16 (1–3): 1–8. doi:10.1159/000087725. hdl:2066/47441. PMID 16121027. S2CID 188974. Archived from the original on 2022-02-11. Retrieved 2022-01-15.
- ↑ Bratosin D, Mazurier J, Tissier JP, et al. (February 1998). "Cellular and molecular mechanisms of senescent erythrocyte phagocytosis by macrophages. A review". Biochimie. 80 (2): 173–95. doi:10.1016/S0300-9084(98)80024-2. PMID 9587675.
- 1 2 Hematology in clinical practice: a guide to diagnosis and management By Robert S. Hillman, Kenneth A. Ault, Henry M. Rinder page 136-139 https://books.google.com/books?id=NJs1VpA8SEoC&pg=PA138&dq=hemoglobin+hemosiderin+hemolysis+bilirubin&ei=Z2P_SuzwA6D2ygT9vOz3Dg#v=onepage&q=hemoglobin%20hemosiderin%20hemolysis%20bilirubin&f=false Archived 2021-12-13 at the Wayback Machine
- ↑ Wintrobe's Clinical Hematology, Volume 1 By John P. Greer https://books.google.com/books?id=68enzUD7BVgC&pg=PA161&dq=hemoglobin+hemosiderin+hemolysis+bilirubin&ei=Z2P_SuzwA6D2ygT9vOz3Dg#v=onepage&q=hemoglobin%20hemosiderin%20hemolysis%20bilirubin&f=false Archived 2021-08-12 at the Wayback Machine page 160
- ↑ Bradencarter (21 January 2017). "What is Hemolytic Anemia?". hemolyticanemia.org. Archived from the original on 2 March 2018. Retrieved 21 January 2017.
- ↑ Boretti FS, Buehler PW, D'Agnillo F, et al. (August 2009). "Sequestration of extracellular hemoglobin within a haptoglobin complex decreases its hypertensive and oxidative effects in dogs and guinea pigs" (PDF). The Journal of Clinical Investigation. 119 (8): 2271–80. doi:10.1172/JCI39115. PMC 2719941. PMID 19620788. Archived (PDF) from the original on 2022-02-11. Retrieved 2022-01-15.
- ↑ "Hemolytic Anemias, F. Spherocytosis". MedicalAssistantOnlinePrograms.org/. Archived from the original on 8 January 2015. Retrieved 6 November 2013.
- ↑ Mary Anna Thrall, Dale C. Baker, E. Duane Lassen, Veterinary hematology and clinical chemistry, ISBN 0-7817-6850-0, 2004.
- ↑ Edward F. Gibbons, Barbara Susan Durrant, Jack Demarest, Conservation of endangered species in captivity: an interdisciplinary approach, page 324, 2005, ISBN 0-7914-1911-8
- ↑ Oliver A. Ryder, Zoological Society of San Diego, Rhinoceros biology and conservation, Zoological Society of San Diego, 1993, page 312, 335.
- ↑ Texas Monthly, Oct 1992, Vol. 20, No. 10, ISSN 0148-7736, page 98-100.
- ↑ Jutta Meister, ed. Catharine E. Bell, Encyclopedia of the world's zoos, Volume 3, page 1008, ISBN 1-57958-174-9, 2001.
- ↑ Kovalkovičová N, Sutiaková I, Pistl J, Sutiak V (2009). "Some food toxic for pets". Interdisciplinary Toxicology. 2 (3): 169–76. doi:10.2478/v10102-009-0012-4. PMC 2984110. PMID 21217849.
External links
| Classification | |
|---|---|
| External resources |
